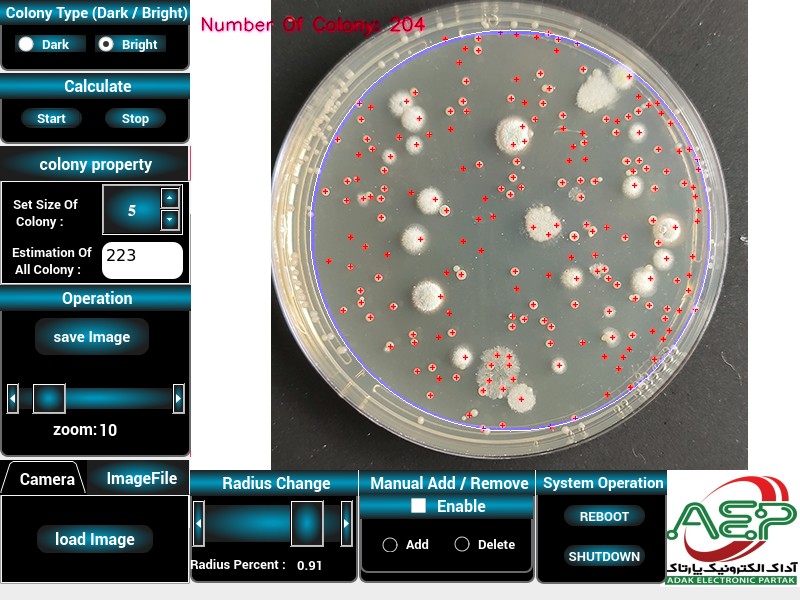

آداک الکترونیک پارتاک
کلنی کانتر اتوماتیک
قیمت: ۱۹۹,۰۰۰,۰۰۰ تومان
دستگاه کلونی شمار خودکار: شمارش سریع و دقیق کلونی ها
دستگاه کلونی شمار خودکار یک سیستم پیشرفته است که برای شمارش سریع و دقیق کلونی های باکتریایی یا سلولی طراحی شده است. این دستگاه با استفاده از تکنیک های پردازش تصویر و الگوریتم های پیشرفته، قادر است کلونی ها را در عرض چند ثانیه شمارش کند و نیاز به شمارش دستی و زمان بر را از بین ببرد.
ویژگی ها و جزئیات فنی:
سخت افزار:
بدنه دستگاه: طراحی ارگونومیک و مقاوم برای استفاده طولانی مدت. سیستم نورپردازی: دارای دو حالت نورپردازی از بالا و پایین: نورپردازی از بالا: مناسب برای محیط های کشت کدر. نورپردازی از پایین: مناسب برای محیط های کشت شفاف. ولوم تنظیم شدت نور: امکان تنظیم دقیق شدت نور برای بهینه سازی تصویربرداری و افزایش دقت شمارش. تکنولوژی نورپردازی LED: استفاده از LED با طول عمر بالا و مصرف انرژی کم. دوربین فیلم برداری: دوربین با کیفیت بالا: ارائه تصاویر واضح و دقیق برای پردازش تصویر. رزولوشن بالا: امکان تشخیص کلونی های کوچک و افزایش دقت شمارش. زوم دیجیتال پیوسته: بزرگنمایی تصاویر برای بررسی دقیق تر کلونی ها. نمایشگر لمسی: صفحه نمایش لمسی: رابط کاربری آسان و بصری برای تنظیمات دستگاه و مشاهده نتایج. اندازه مناسب نمایشگر: نمایش واضح تصاویر و اطلاعات مربوط به شمارش. مینی کامپیوتر: پردازنده قدرتمند: اجرای سریع الگوریتم های پردازش تصویر. حافظه داخلی: ذخیره سازی نتایج شمارش و تصاویر. پورت های USB و HDMI: امکان اتصال به حافظه های خارجی و نمایشگرهای بزرگتر.
نرم افزار:
رابط کاربری: رابط کاربری آسان و قابل فهم: سهولت استفاده برای کاربران با سطوح مختلف تجربه. نمایش زنده تصاویر: مشاهده مستقیم نمونه در حال آزمایش. ذخیره سازی و بارگذاری تصاویر: امکان ذخیره نتایج و بارگذاری تصاویر از قبل تهیه شده. الگوریتم های پردازش تصویر: الگوریتم های پیشرفته: تشخیص دقیق کلونی ها با اندازه ها و رنگ های مختلف. سرعت پردازش بالا: شمارش سریع کلونی ها در کسری از ثانیه. قابلیت اصالح شمارش: امکان اصالح دستی نتایج شمارش برای افزایش دقت.
مزایا:
سرعت: شمارش کلونی ها در کسری از ثانیه، در مقایسه با روش های دستی که زمان بر و خسته کننده هستند. دقت: الگوریتم های پیشرفته پردازش تصویر، دقت بالایی در شمارش کلونی ها ارائه می دهند و احتمال خطا را کاهش می دهند. دقت گزارش شده 88% در شمارش کاملا خودکار. کارایی: صرفه جویی در زمان و هزینه های نیروی انسانی. سهولت استفاده: رابط کاربری آسان و بصری، امکان استفاده آسان برای کاربران با سطوح مختلف تجربه. قابلیت اطمینان: عملکرد پایدار و قابل اعتماد در طولانی مدت. تطبیق پذیری: امکان شمارش کلونی ها در انواع محیط های کشت و با اندازه ها و رنگ های مختلف. ذخیره سازی و گزارش دهی: ذخیره سازی نتایج شمارش و تصاویر برای مستند سازی و تحلیل های بعدی. بهینه سازی: قابلیت به روز رسانی نرم افزار برای افزایش دقت و کارایی در آینده.
مشخصات فنی:
| ویژگی | مشخصات |
|---|---|
| تغذیه ورودی | برق شهری 220 ولت |
| پورت ها | 2 پورت USB (اتصال حافظه فلش و موس)، خروجی تصویر HDMI |
| نورپردازی | قابلیت تنظیم زاویه نورپردازی (بالا/پایین)، ولوم تنظیم شدت نور |
| دوربین | دوربین 8Mp با کیفیت بالا و رزولوشن مناسب |
| نمایشگر | نمایشگر لمسی |
| مینی کامپیوتر | دارای مینی کامپیوتر داخلی |
| الگوریتم شمارش | الگوریتم های پیشرفته پردازش تصویر |
| قابلیت اصالح | امکان اصالح شمارش توسط کاربر |
| ذخیره سازی | امکان ذخیره نتایج شمارش |
| زوم | زوم دیجیتال پیوسته |
مزایای جدید نسبت به مدل های قبلی و رقبا:
- کامپیوتر داخلی: عدم نیاز به کامپیوتر یا لپ تاپ، سهولت در استفاده و کاهش هزینه ها.
- نورپردازی قابل تنظیم: تنظیم زاویه و شدت نور برای بهینه سازی تصویربرداری و افزایش دقت شمارش در محیط های کشت مختلف.
- قیمت مناسب: قیمت رقابتی در مقایسه با نمونه های خارجی.
- خدمات پس از فروش: ضمانت و خدمات پس از فروش در دسترس.
- به روز رسانی نرم افزار: امکان به روز رسانی نرم افزار برای افزایش دقت و کارایی در آینده.
- تست در محل: امکان تست دستگاه در محل قبل از خرید.
- بهینه سازی نرم افزار: قابلیت بهینه کردن نرم افزار دستگاه با توجه به نوع نمونه های مورد نظر مشتری.
مزایای عملکردی:
- افزایش سرعت شمارش: شمارش کلونی ها در کسری از ثانیه، در مقایسه با روش های دستی.
- افزایش دقت شمارش: الگوریتم های پیشرفته پردازش تصویر، دقت بالایی در شمارش کلونی ها ارائه می دهند. دقت گزارش شده 88% در شمارش کاملا خودکار.
- کاهش خطای انسانی: حذف خطاهای ناشی از شمارش دستی.
- بهبود مستند سازی: ذخیره سازی نتایج شمارش و تصاویر برای مستند سازی و تحلیل های بعدی.
دستگاه کلونی شمار خودکار یک ابزار قدرتمند و کارآمد برای آزمایشگاه ها و مراکز تحقیقاتی است که نیاز به شمارش دقیق و سریع کلونی ها دارند. این دستگاه با ویژگی های پیشرفته، سهولت استفاده و قیمت مناسب، یک انتخاب عالی برای بهبود کارایی و دقت در شمارش کلونی ها است. برای کسب اطلاعات بیشتر و خرید دستگاه، لطفا با ما تماس بگیرید.